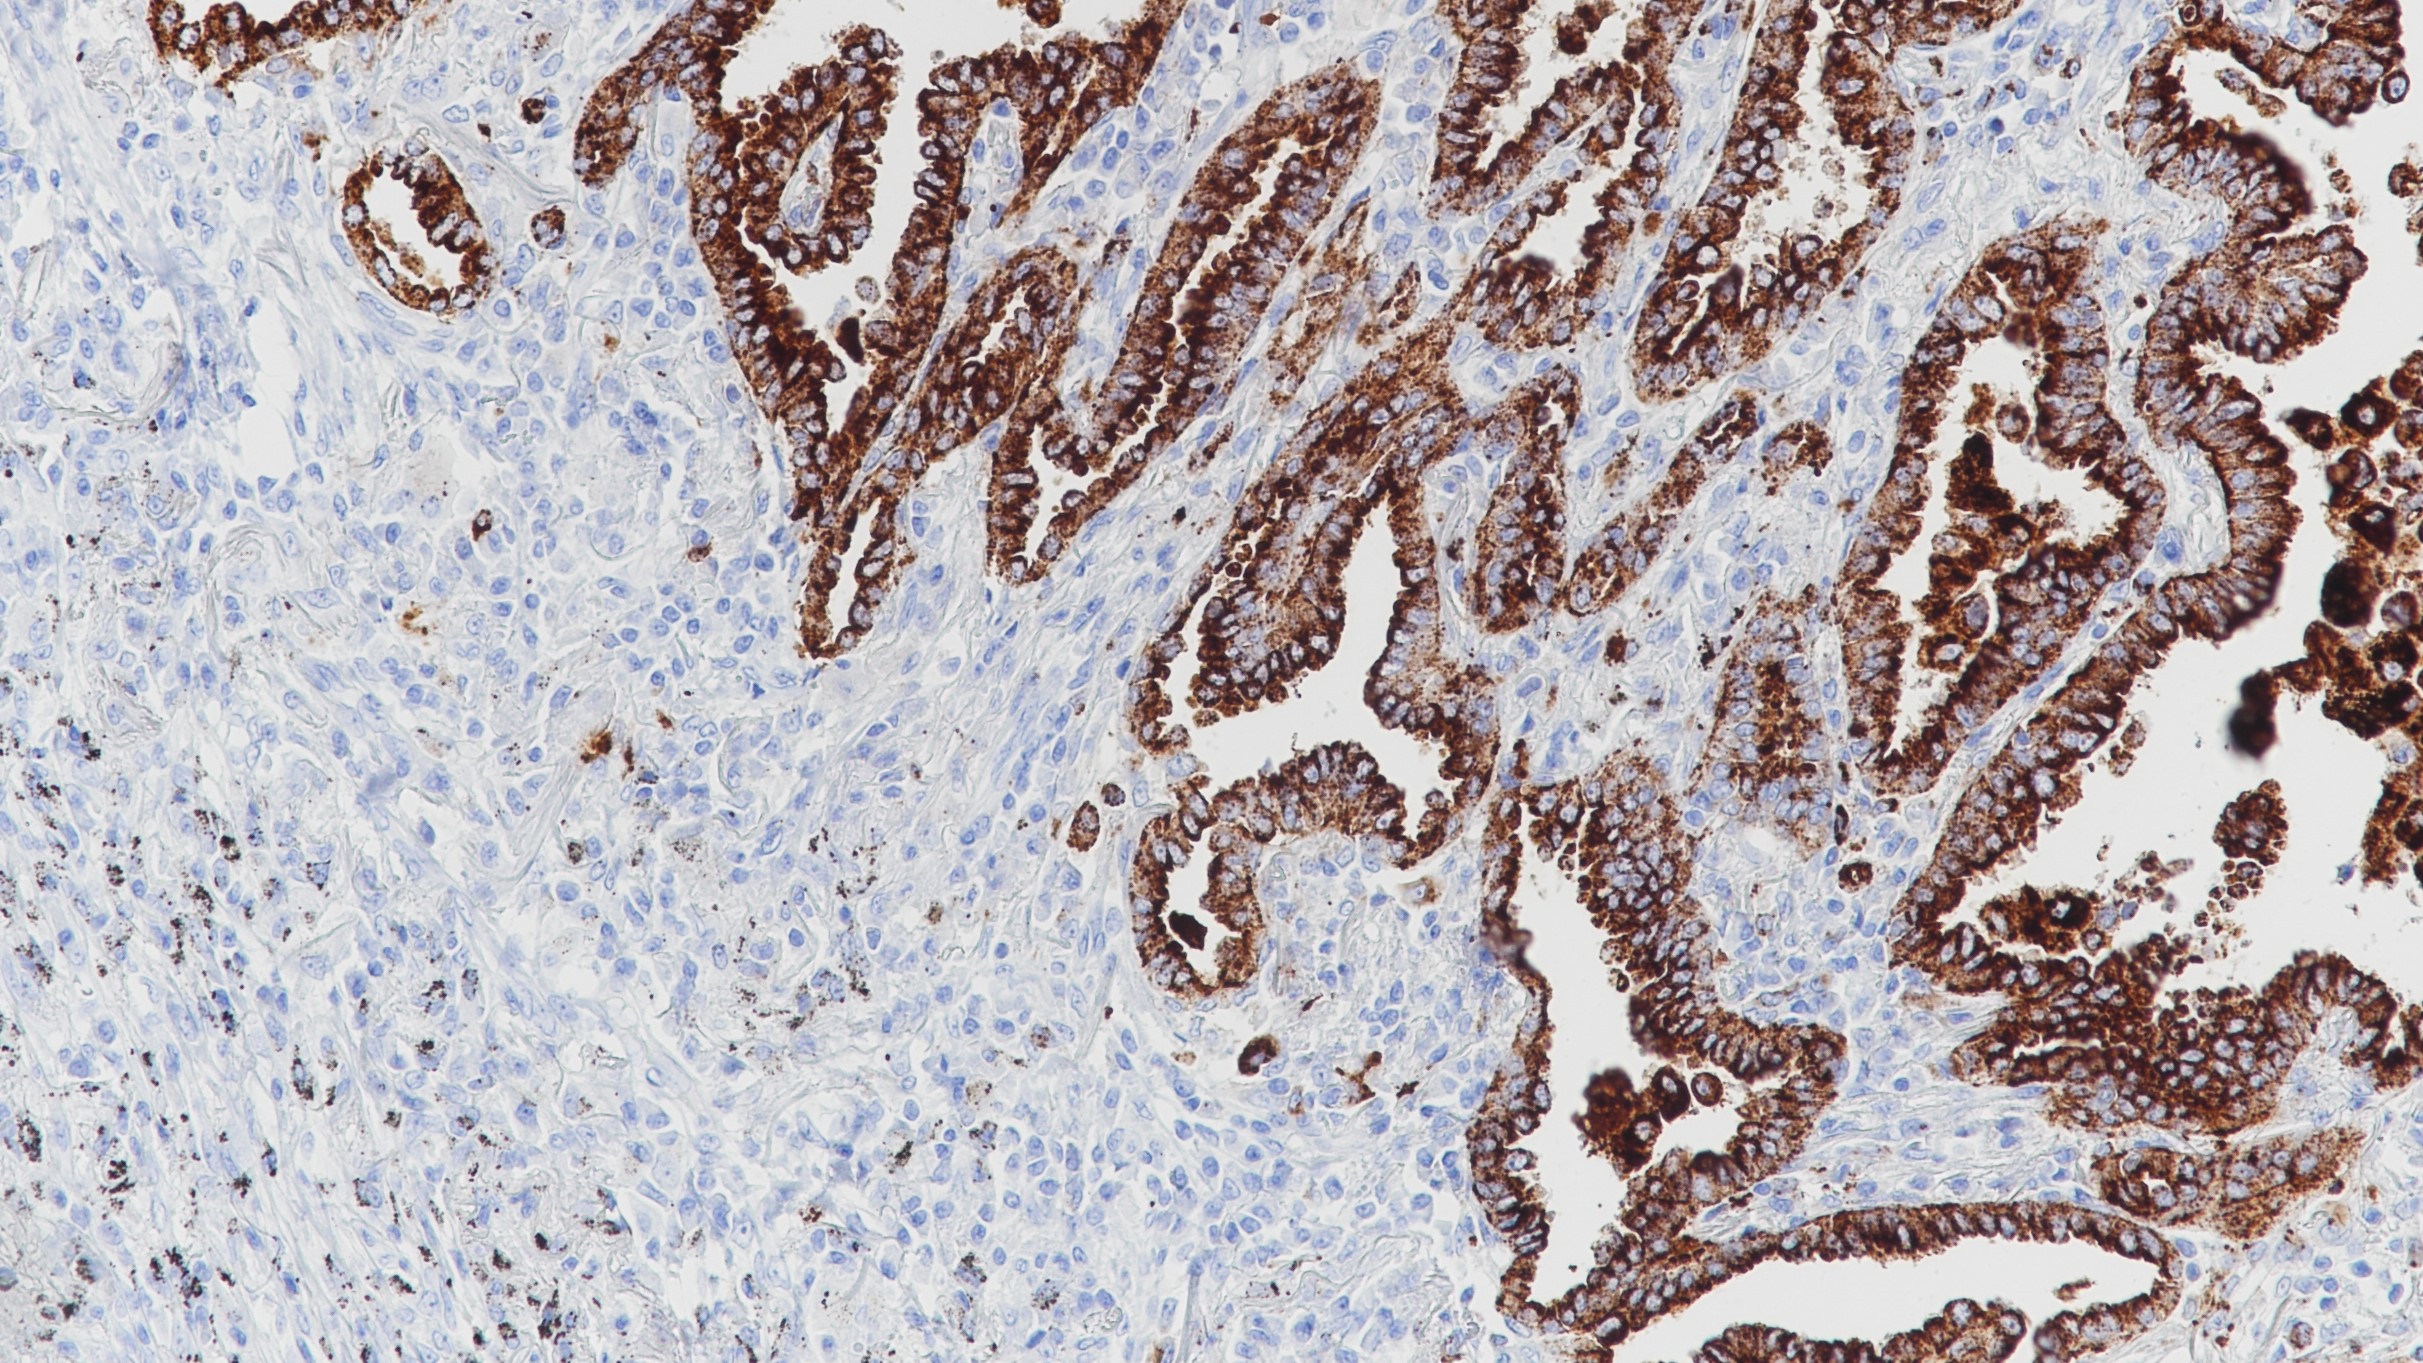
肺腺癌Napsin A (BP6083)染色

1. Bishop J A, Sharma R, Illei P B. Napsin A and thyroid transcription factor-1 expression in carcinomas of the lung, breast, pancreas, colon, kidney, thyroid, and malignant mesothelioma.[J]. Human Pathology, 2010, 41(1):20-25.
2. Turner B M, Cagle P T, Sainz I M, et al. Napsin A, a new marker for lung adenocarcinoma, is complementary and more sensitive and specific than thyroid transcription factor 1 in the differential diagnosis of primary pulmonary carcinoma: evaluation of 1674 cases by tissue microarray.[J]. Archives of Pathology & Laboratory Medicine, 2012, 136(2):163-171.
3.中华医学会.《临床技术操作规范·病理学分册》.人民军医出版社,2004.